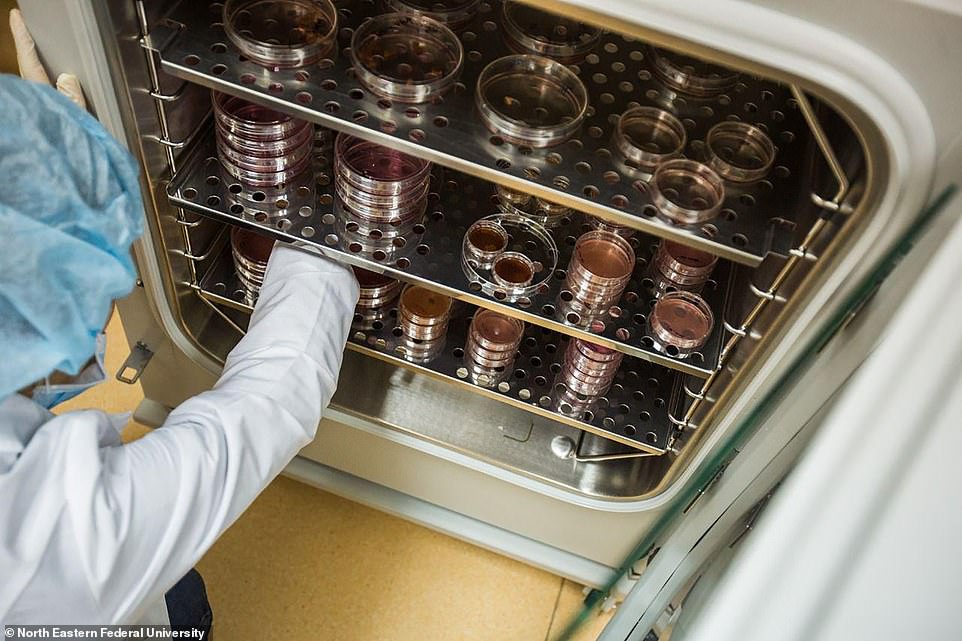

科学家计划克隆4.2万年前已灭绝小马
【环球网科技综合报道】据英国《每日邮报》4月10日报道,科学家们通过提取42000年前灭绝小马驹的细胞,克隆这种史前动物,并且很有信心这次任务能够圆满完成。

专家称,这种浅黄色的小马驹出生不到两周就死了,但是其躯体在西伯利亚冻土上近乎完美的保存了下来,时间长达42170年。一个由俄罗斯和韩国专家组成的研究队在对这匹冰冻的小马驹进行了几个月紧锣密鼓的研究后,愈加自信能借助获得的细胞,尝试克隆这种抗冻灭绝物种。这项任务将会持续到今年4月底。这是一项尖端工作,研究人员说他们正在计划为这匹小马驹选择代孕妈妈。国际研究队专家称想使用猛犸的躯体。

该研究队中一位来自俄罗斯的主要研究人员称7位科学家参与了这次任务,并且每个人对成果都信心满满。这位研究人员还说第一次克隆尝试可能让一匹韩国母马做作代孕妈妈。匹配度会非常高。因为这类母马经常扮演代孕的角色而且目前科学技术也非常成熟,成功率会很高。另外,这类母马是蒙古马的后代,品种也非常古老。

另一种选择是使用雅库特马——一种东西伯利亚当地物种。冬天低温至零下60摄氏度的时候,它们依旧能生存。雅库特猛犸博物馆的研究人员称,因为这种动物的肌肉组织很好的保存了下来,所以我们能得到样本进行生物科技研究。(实习编译:王玉琛 审稿:李宗泽)











【环球网科技综合报道】据英国《每日邮报》4月10日报道,科学家们通过提取42000年前灭绝小马驹的细胞,克隆这种史前动物,并且很有信心这次任务能够圆满完成。
专家称,这种浅黄色的小马驹出生不到两周就死了,但是其躯体在西伯利亚冻土上近乎完美的保存了下来,时间长达42170年。一个由俄罗斯和韩国专家组成的研究队在对这匹冰冻的小马驹进行了几个月紧锣密鼓的研究后,愈加自信能借助获得的细胞,尝试克隆这种抗冻灭绝物种。这项任务将会持续到今年4月底。这是一项尖端工作,研究人员说他们正在计划为这匹小马驹选择代孕妈妈。国际研究队专家称想使用猛犸的躯体。
该研究队中一位来自俄罗斯的主要研究人员称7位科学家参与了这次任务,并且每个人对成果都信心满满。这位研究人员还说第一次克隆尝试可能让一匹韩国母马做作代孕妈妈。匹配度会非常高。因为这类母马经常扮演代孕的角色而且目前科学技术也非常成熟,成功率会很高。另外,这类母马是蒙古马的后代,品种也非常古老。
另一种选择是使用雅库特马——一种东西伯利亚当地物种。冬天低温至零下60摄氏度的时候,它们依旧能生存。雅库特猛犸博物馆的研究人员称,因为这种动物的肌肉组织很好的保存了下来,所以我们能得到样本进行生物科技研究。(实习编译:王玉琛 审稿:李宗泽)
版权作品,未经环球网 huanqiu.com 书面授权,严禁转载,违者将被追究法律责任。